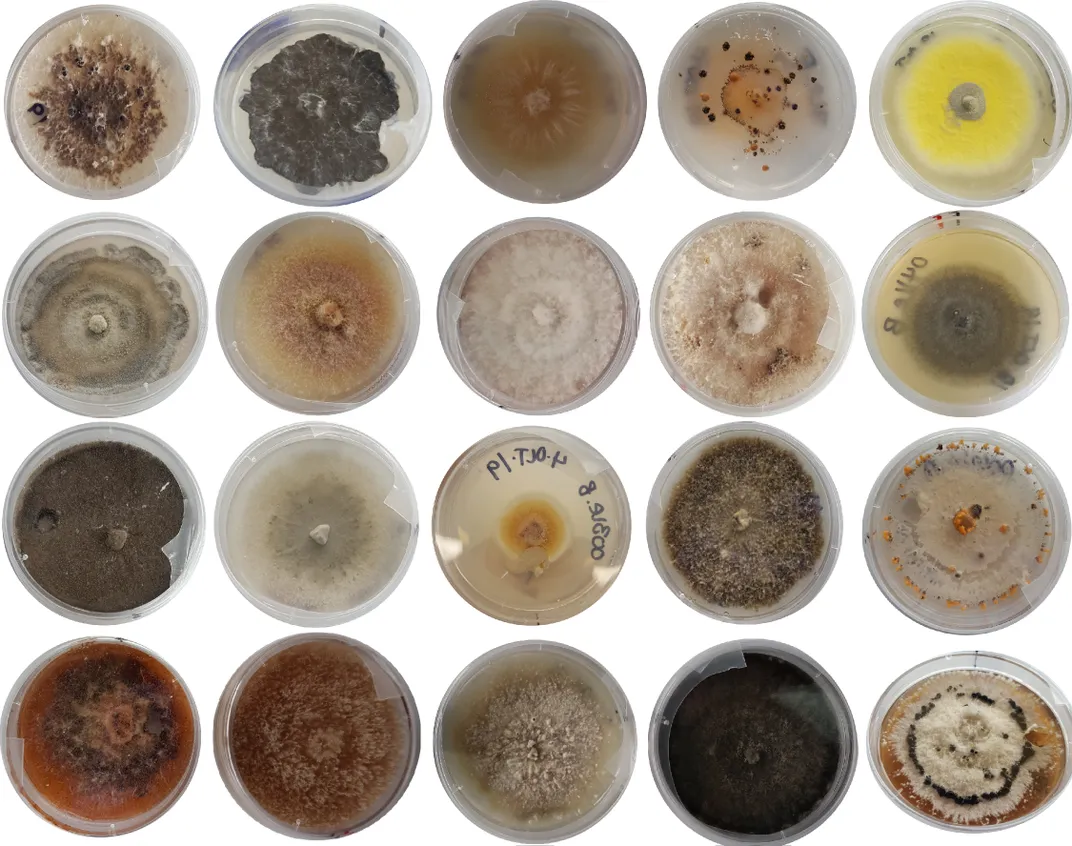
Fungi growing in petri dishes.

Five unexpected facts about forests

The Smithsonian Forest Global Earth Observatory (ForestGEO) is a global network of scientists and forest research sites dedicated to advancing long-term study of the world's forests. Image credit: Smithsonian Tropical Research Institute
While only one third of all the land on Earth is covered by forests, around eighty percent of land animals and plants call forests home. Not only are trees critical support systems for biodiversity, but they also capture carbon, prevent flooding, create shade, produce the oxygen we breathe, and improve our health.
When you manage a global network of scientists and forest research sites accounting for seven million trees, you’ve been leading research on the oldest continuously studied forest in the world, you’ve been intentionally flooding patches of forest to see how they will respond, and you’ve housed and cared for the actual Smokey Bear after he was rescued from a forest fire, you tend to gather some knowledge about forests along the way. Here are five forest facts backed by Smithsonian research.
A healthy forest is one that is ripe with fungal diseases.
If you’re reading this somewhere in the U.S. or Canada right now, chances are most of the trees in the nearest forest belong to only four or five species. But if you’re lucky enough to be hanging out in the tropics, look around…you might notice that in a tropical rainforest, an area the size of a baseball field can contain more than 166 different tree species. According to Erin Spear’s research at the Smithsonian Tropical Research Institute, you can thank fungal disease for that.
Diversity in a forest makes it resilient—different species are less likely to compete for the same resources or be affected in the same way by environmental challenges, like climate change. Fungal diseases keep individual tree species’ populations in check, so the stronger ones don’t dominate, thereby maintaining the biodiversity of tropical forests. Erin’s DEATH (Disease Ecology Across Tropical Habitats) Lab studies how and why this happens.
A diverse forest benefits animals, plants, humans.

We are currently living in the United Nations Decade of Restoration, a rallying call for restoring global ecosystems for the benefit of people and nature. And that includes reforesting land. But if you were tasked with replanting a forest, where would you start? How many tree species would you plant? What species would you select to ensure your forest grows strong and healthy? Ten years ago, to start a 100-year research and restoration project called BiodiversiTREE, John Parker and his team planted 18,000 trees across 70 plots at the Smithsonian Environmental Research Center to find out.
Each of the 70 planted plots has either one tree species (called a monoculture), four species, or 12 species. There are also five additional “control” plots the team left alone to regrow naturally. The whole experiment takes up over 60 acres—you'd have to walk 27 miles to inspect every tree. If you walk through the plots, you’ll notice some stark differences.
The monocultures are a tale of extremes—some have tall, narrow trees racing each other to the top, while others barely got off the ground because of deer browsing or other misfortune. The most diverse plots have trees of all shapes and sizes, with some trees growing tall and stately, and some branching out horizontally to fill in the lower canopy gaps. Surprisingly, most of the diverse plots already resemble the nearby mature forests, and they’re well ahead of the control plots (which, in fact, most resemble the one species plots). The four-species plots are somewhere in the middle of these extremes.
Ten years into this experiment, Parker and a large, collaborative team have already found that the more diverse plots feature bigger trees, richer soil, more diverse animal communities living within them, and lower ambient temperatures, making them more comfortable for us and the plants and animals that depend on forests for survival. The BiodiversiTREE project shows us the multiple benefits of tree diversity in forest ecosystems, information that will be critical to smart and sustainable forest restoration.
Tropical forests likely host the highest number of undiscovered species.

Scholars have described about 8.7 million species globally, and they estimate an additional five million are waiting to be discovered. Altogether, it’s likely most of these species live in tropical rainforests, the most diverse ecosystems on the planet. The National Museum of Natural History (NMNH) and the Smithsonian’s National Zoo and Conservation Biology Institute (NZCBI) are leading the search because they know that species discovery helps us learn how to conserve one of the world’s most delicate and essential ecosystems.
Researchers from the NZCBI, for example, found the olive-backed forest robin in the tropical backwoods of Gabon. NMNH scientists found the olinguito (o-ling-GWEE-toe)—the first carnivore discovered in 35 years—in a South American cloud forest. David de Santana (also at NMNH) and his colleagues tripled the number of known electric eel species and discovered the world’s most powerful biological electric shock in the Amazon basin. There might be even more that live in the tropical forest canopy and never come down to the ground—just ask NZCBI conservation biologist Tremie Gregory. Altogether, discoveries like these can inform conservation efforts around the world and help us create a more sustainable planet for all living things.
Coffee and cocoa can be grown without hurting tropical forests.

Research led by scientists at NZCBI found that cocoa farms and forests can coexist sustainably to protect native bird species. Cocoa farms simply need 30 to 40 percent canopy cover and diverse shade trees, and they could support as many bird species as undisturbed forests. Based on these findings, Smithsonian Migratory Bird Center researchers developed the certification standard for Bird Friendly ™ cocoa. Cocoa is the second crop type certified by the Smithsonian Bird Friendly program, following coffee.
Instead of clearing rainforest, Bird Friendly cocoa grows as these crops naturally would without human intervention: under and alongside the shade of native trees that provide food and shelter for birds and other wildlife. All Bird Friendly certified cocoa meets strict environmental criteria developed by Smithsonian scientists, assessing for qualities like canopy cover, tree height, and organic certification, resulting in the most biodiversity-friendly chocolates on the market.
Paying people to replant tropical forests—and letting them harvest the timber—can pay off for climate, justice, and the environment.

Millions of Indigenous peoples and family farmers call tropical forests home, and it’s up to us humans to take care of these fragile landscapes. Reforesting deforested tropical landscapes is not easy, but in a study, Jefferson Hall from the Smithsonian Tropical Research Center and colleagues showed how paying local landowners to plant trees and harvest their timber in tropical forests benefits everyone involved.
The team took about 1.4 million tree measurements over 15 years at the Smithsonian Tropical Research Institute’s Agua Salud site and estimated future carbon sequestration numbers and potential timber revenues. They found that by paying landowners to plant trees (thereby sequestering carbon) and by giving them the agency to sell timber from trees on their land, they could create both vibrant forests and financial gains for the landholder.
Jeff will be the first to admit that this approach may not be economically efficient in the short term, but it’s a win-win solution and demonstrates a potential path forward that balances two often-conflicting interests: conserving the tropical rainforest while continuing to grow the local economy.
People and Planet Working Together
Viewing the breadth of the Smithsonian’s forest research, it becomes clear that saving forests does not have to come at the expense of economic prosperity. Scientists are working in virtually every forest ecosystem in the world, in collaboration with local partners and communities, to understand the ecology of forests while informing sustainable solutions to deforestation and other challenges to the environment. By respecting all species—birds, humans, eels, and fungi alike—we can create a better world for everyone.